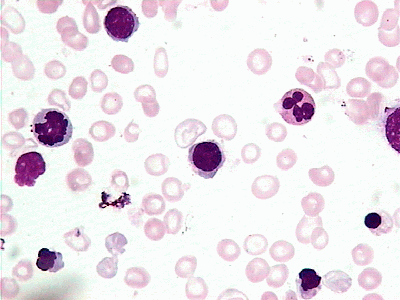
指与人类本能有关的行为活动,包括生存本能,防御本能,食欲性欲本能等

缺铁性贫血骨髓报告单

缺铁影响大脑发育?你不知道宝宝缺铁的n种危害!
图片尺寸942x1154
这些指标直接告诉你!
图片尺寸1080x434
女子缺铁性贫血1年竟得结肠癌有这些症状要小心
图片尺寸602x317
骨髓报告pas染色骨髓涂片免疫检测生化检查血细胞分析实验室相关检查
图片尺寸1035x1146
缺铁性贫血药物,您了解吗?_铁剂_mg_儿童
图片尺寸1326x1232
每日技能病例分析之缺铁性贫血
图片尺寸603x537
2例境外输入性无症状感染者已转至定点医疗机构医学观察,已追踪同航班
图片尺寸473x788
血清浓度13) (1)单次给药 :测定健康男子单次静脉(1,10,20,40 ug /人)
图片尺寸220x146
关于缺铁性贫血的科普小知识
图片尺寸640x552
图片浏览
图片尺寸126x139
一位缺铁性贫血患者的外周血涂片
图片尺寸220x165
做了检查后,血常规检验单结果提示该患者系中重度小细胞低色素性贫血
图片尺寸529x545
思维导图记忆缺铁性贫血的重要考点
图片尺寸1080x943指与人类本能有关的行为活动,包括生存本能,防御本能,食欲性欲本能等
图片尺寸400x300
关于血液病您知道多少?一文揭秘血液病的类型,症状与治疗
图片尺寸1000x1482
淋巴瘤,多发性骨髓瘤等;贫血性疾病如再生障碍性贫血,缺铁性贫血,巨幼
图片尺寸1080x1521
72% 的年轻女性都没吃够它,缺乏容易头晕,疲惫,易激怒
图片尺寸1080x10942
十月呵护小心宝宝缺铁性贫血
图片尺寸1280x720
缺铁性贫血症
图片尺寸268x236
缺铁性贫血|血红素铁|食补_新浪育儿_新浪网
图片尺寸550x309
猜你喜欢:缺铁性贫血报告单图片缺铁性贫血报告单骨髓报告单缺铁性贫血骨髓象缺铁性贫血骨髓象报告缺铁性贫血检验报告单缺铁性贫血骨髓缺铁性贫血骨髓涂片贫血骨髓报告单缺铁性贫血骨髓片缺铁性贫血骨髓象特点缺铁性贫血骨髓象图片缺铁性贫血血常规缺铁性贫血的化验单缺铁性贫血化验单缺铁性贫血血象缺铁性贫血血涂片白血病骨髓报告单缺铁性贫血红细胞缺铁性贫血骨髓检查报告单缺铁性贫血病人正常骨髓报告单缺铁性贫血的症状缺铁性贫血怎么补最快缺铁性贫血ppt骨髓报告单正常值儿童缺铁性贫血缺铁性贫血鉴别诊断缺铁性贫血性白斑图片y≡2sinx图像高山滑雪壁纸吃鸡地铁逃生模式该账号已注销头像河南钻姐畸形动物图片大全集毛毛虫变蝴蝶绘画过程辞职图片 不干KT简笔画 哈喽最强肌肉女 发达共享雨伞插画图欧米茄1020